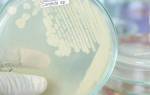

Анжелик при климаксе: показания, противопоказания и особенности препарата
Климактерический период включает несколько фаз, которые сопровождаются нарушением гормонального фона. Это провоцирует развитие ряда неприятных симптомов, мешающих в повседневной жизни. Препарат Анжелик при климаксе способствует выравниванию гормонов, что сглаживает течение климакса. Имеются противопоказания и побочные реакции, поэтому перед началом использования необходимо проконсультироваться с доктором.
Состав и форма выпуска
Фармацевтическое средство выпускается в форме двояковыпуклых таблеток для приема внутрь. Они имеют круглую форму, серо-розовый цвет и расфасованы в блистеры по 28 штук. Блистер упакован в картонную коробку, к нему также прилагается инструкция по применению. Стоимость упаковки средства составляет приблизительно 1300 руб.
В качестве активных компонентов в составе лекарства выступают гормональные вещества эстрадиол и дроспиренон.
Помимо этого, в лекарстве имеются вспомогательные ингредиенты:
- Магния стеарат.
- Крахмал кукурузный.
- Тальк.
- Повидон.
- Макрогол.
- Желатин.
- Лактозы моногидрат.
- Краситель.
Анжелик таблетки от климакса
Вспомогательные ингредиенты не оказывают терапевтического воздействия, но необходимы для сохранения химического состава средства. Основные ингредиенты обладают несколькими фармакологическими свойствами.
Механизм действия
Анжелик таблетки от климакса оказывают выраженное действие на организм женщины при появлении первых признаков климакса. Они восполняют дефицит эстрогена, уровень которого резко снижается в период менопаузы. При этом снижается частота приливов, нормализуется менструальный цикл, исчезает дискомфорт во влагалище, связанный с сухостью и дисбактериозом.
Дополнительно снижается к минимуму риск критического опущения стенок влагалища и мочевого пузыря. Подобное отклонение считается частым нарушением при климаксе, поскольку эстроген принимает активное участие в поддерживании тонуса мышц малого таза.
Важным свойством действующих компонентов средства считается нормализация гормонального баланса пациентки. При этом устраняются такие симптомы, как резкая смена настроения, раздражительность, расстройство сна.
Женщина чувствует себя гораздо лучше, чем до начала употребления медикамента. Помимо этого, средство позволяет предотвратить ухудшение состояния волос и кожных покровов, которые часто страдают при нарушении гормонального равновесия.
Стоит также отметить, что медикамент позволяет не только нормализовать менструальный цикл, но и предотвращает обильные кровотечения, которые нередко наблюдаются в период менопаузы.
Эстрадиол в составе медикамента позволят снизить вероятность потери костной массы и развития остеопороза. Заболевание является наиболее частой проблемой женщин при наступлении климакса, провоцирует частые переломы и трудности при восстановлении пациентки.
Дополнительно вещество замедляет процесс старения кожного покрова, образование морщин и предупреждает появление возрастной пигментации за счет регулирования выработки меланина.
Дроспиренон в составе лекарства также оказывает выраженное действие, предотвращает резкие перепады артериального давления, стимулирует выведение из организма воды и солей.
Благодаря этому снижается вероятность увеличения массы тела. Помимо этого, компонент является синтетическим аналогом прогестерона, оказывает щадящее воздействие и не провоцирует осложнения при условии правильного применения.
После попадания в пищеварительный тракт препарат быстро и почти полностью усваивается. Его действующие компоненты перерабатываются в печени. Выведение большего количества продуктов распада осуществляется через кишечник, небольшая доля компонентов выходит с мочой.
Период полного выведения метаболитов из организма занимает не более 5 дней. У пациентов с тяжелыми патологиями пищеварительной и мочевыделительной системы время эвакуации компонентов из организма увеличивается на несколько часов.
Показания к применению
Анжелик имеет довольно длинный список показаний. Таблетки используются не только от климакса, но и могут входить в состав комплексного лечения других заболеваний.
Основные показания для использования:
- Нарушение гормонального баланса, сопровождающееся дефицитом эстрогена.
- Тяжелое течение менопаузы, характеризующееся частыми приливами, повышение артериального давления и резкой сменой настроения.
- Обильные менструальные кровотечения.
- Дискомфорт и сухость во влагалище, развитие воспаления или дисбактериоза.
- Боль в молочных железах, связанная с резким изменением гормонального фона.
Помимо этого, препарат может применяться в качестве профилактического средства с целью предупреждения остеопороза и других осложнений со стороны опорно-двигательного аппарата.
Изменения в организме женщины при климаксе
Климактерические изменения, происходящие в женском организме, прежде всего выражаются в прекращении выработки яичниками и надпочечниками гормонов.
Происходит значительное изменение режима функционирования всех систем организма, которые очень глубоко были встроены в эндокринную систему, а также тем или иным образом взаимодействовали с ней.
Такие изменения часто весьма болезненно воспринимаются женщинами — проявляют себя ранее незаметные хронические заболевания, возникают неприятные ощущения психологического дискомфорта и неустойчивые эмоциональные состояния. Появляется вазомоторная нестабильность, именуемая в обиходе «приливами», обостряются сердечно-сосудистые и прочие заболевания.
Противопоказания и побочные действия
Несмотря на эффективность лекарства, его не всегда разрешается использовать. К абсолютным противопоказаниям относится непереносимость основного или вспомогательных компонентов средства. В период лечения другими гормональными медикаментами Анжелик также лучше не использовать.
Противопоказано средство при печеночной и почечной недостаточности тяжелой формы, а также поражении желчного пузыря с образованием в нем камней. Женщинам с тромбофлебитом не назначают медикамент.
Не стоит его применять и при склонности к тромбообразованию, сгущении крови или патологическом повышении уровня тромбоцитов. Острая язвенная болезнь желудка и двенадцатиперстной кишки считается препятствием для терапии.
Многие пациентки в период климакса отмечают обострение гипертонической болезни и повышение показателей до критических цифр. В этом случае таблетки употреблять не стоит, поскольку они могут только ухудшить состояние. Еще одним препятствием для приема средства считается период восстановления после оперативного вмешательства на органах брюшной полости, а также после перенесенного инфаркта миокарда.
С осторожностью медикамент используется при эпилепсии, сердечной недостаточности и бронхиальной астме в анамнезе пациентки. При сахарном диабете, тяжелой форме ожирения решение о назначении лекарства принимает только врач.
При нарушении инструкции возможно развитие побочных реакций со стороны органов и систем. Стоит отметить, что осложнения могут наблюдаться и при соблюдении всех рекомендаций.
| Органы и системы | Симптомы |
| Нервная система | Головная боль, бессонница, апатия. У пациенток отмечается снижение работоспособности, расстройство внимания и ухудшение памяти. При этом симптомы могут проявляться на некоторое время и самостоятельно исчезать, иногда они постоянно присутствуют, что ухудшает состояние женщины. |
| Пищеварительная система | Тошнота и рвота часто проявляется при приеме гормональных медикаментов. Симптоматика может сопровождаться метеоризмом, болью в области желудка и кишечника, спазмами. Иногда женщины говорят о стойком запоре, у некоторых наблюдается жидкий стул. |
| Сердце и сосуды | Тахикардия и повышение показателей АД в большинстве случаев появляется у пациенток, которые страдают какими-либо хроническими патологиями со стороны сосудов и сердца. Помимо этого, возможно тромбообразование у больных, имеющих к этому склонность. |
| Мочеполовая система | У многих пациенток отмечается снижение либидо, а также нарушение цикла, проявляющееся в виде обильных и частых маточных кровотечений, которые не связаны с циклом. Помимо этого, повышается вероятность развития вагиноза, эндометрита, молочницы. |
| Кожные покровы | Сыпь и раздражение кожных покровов появляется редко, обычно сопровождается шелушением и легким зудом. |
Дополнительно возможно усиленное потоотделение, боли в мышцах и суставах, увеличение массы тела или критическое ее снижение. Некоторые женщины говорят об ухудшении аппетита, изменении вкусовых предпочтений.
Болезни, при которых таблетки принимают под контролем врача
При некоторых заболеваниях препарат можно принимать, но в некоторых случаях его придется отменить.
Перед назначением врач проведет много диагностических процедур.
Поэтому, если дама имеет следующие заболевания, то ей понадобится более тщательный контроль приема таблеток:
- сахарный диабет;
- хроническая сердечная недостаточность;
- начальная стадия гиперплазии эндометрия;
- эндометриоз (клетки эндометрия разрослись на тканях других органов);
- миома матки (доброкачественное новообразование);
- все болезни желчного пузыря;
- холестатическая желтуха или зуд (нарушен отток желчи в двенадцатиперстную кишку);
- синдромы Жильбера, Дубина-Джонсона или Ротора (наследственные заболевания, при которых периодически проявляется желтушность кожи);
- наследственная предрасположенность к развитию тромбозов и тромбоэмболии в молодом возрасте;
- красная волчанка (иммунная система воспринимает клетки организма, как чужеродные и уничтожает их);
- деменция (приобретенное слабоумие, по разным причинам начинается ухудшение памяти, деградация мышления и социального поведения);
- тромбоз сосудов сетчатки;
- умеренная форма гипертриглицеридемии (повышенный уровень триглицеридов в плазме крови натощак);
- тяжелая гипокальциемия (недостаточность кальция в организме);
- гиперкалиемия (избыток калия в организме);
- гиперхолестеринемия (повышенный уровень холестерина в крови).
- гемангиомы печени (врожденные доброкачественные опухоли);
- бронхиальная астма;
- эпилепсия;
- мигрень;
- ожирение.
Особого контроля лечащего врача за процессом лечением требует дама, которая имеет большой стаж курения.
Особые указания
Анжелик таблетки от климакса не стоит использовать на протяжении длительного периода без предварительного обследования специалиста. Обычно врачи перед началом курса назначают анализ крови для определения уровня половых гормонов.
При появлении признаков дисбактериоза влагалища возможно дополнительное применение суппозиториев для нормализации микрофлоры. Действие таблеток не зависит от приема пищи, поэтому разрешается употреблять их во время еды или независимо от этого.
Если женщина страдает частыми мигренями, следует употреблять препарат с осторожностью. Обычно врач назначает его короткими курсами, наблюдает за состоянием пациентки. При усугублении мигрени медикамент отменяют и назначают другое комбинированное средство.
Положительный эффект от приема препарата
Современные стратегии применения ЗГТ во время климактерического периода, как раз базируются на использовании микродоз женских половых гормонов. Важно чтобы ЗГТ препаратом Анжелика Микро имела непрерывный характер. В таком случае у пациентки не будет регулярных кровотечений, которые часто случаются, при проведении ЗГТ циклами.
У некоторых дам первые месяцы применения ЗГТ даже микродозами гормонов вызывает мажущие выделения или кровотечения. Это не является причиной прекращения лечения. Со временем частота выделений будет сокращаться. Действие гормонального препарата проявляется через 2 недели от начала его приема. Максимальный эффект следует ожидать через 6 недель от старта ЗГТ.
Дозировка и комбинация активных веществ гормонального препарата эффективно препятствует дальнейшему развитию возникшей у дамы ранее гиперплазии эндометрия. Результаты проведенных производителем исследований показали, что у 71-77% женщин, принимающих препарат на протяжении года, было зафиксировано атрофию эндометрия.
Применение лекарственного препарата не вызывает оттеков. У пациенток, страдающих гипертонией, постоянное применение микродоз гормонов приводит к снижению артериального давления. Поэтому, очень многие «гипертоники со стажем» после 8 недель применения этого препарата либо снижают дозы применяемых ими лекарств, либо вовсе от них отказываются.
Некоторые показатели после приема Анжелик.
Передозировка
При употреблении рекомендуемой дозы средства передозировка не развивается.
Однако при приеме сразу нескольких таблеток усугубляются все побочные реакции:
- Сильная тошнота и рвота. Опорожнение желудка не облегчает состояния женщины.
- Маточное кровотечение.
- Слабость и критическое снижение показателей артериального давления.
- Сильная головная боль.
- Потеря сознания.
- Сильный зуд кожных покровов, появление на теле мелких пузырьков, наполненных прозрачной жидкостью.
- Образование участков раздражения и повышение риска присоединения инфекции.
В тяжелых случаях развивается отек Квинке, при котором в процесс вовлекается слизистая оболочка горла и верхнего неба. Отек провоцирует нарушение дыхания, вплоть до удушья. Подобные проявления считаются поводом для немедленного прекращения приема средства. Обычно симптомы исчезают через несколько часов или же ослабляются. Если же этого не произошло, необходимо немедленно обратиться к специалисту за помощью.
Инструкция по применению
Поскольку медикамент относится к комбинированным гормональным средствам, принимать его необходимо, соблюдая некоторые правила. Осуществлять прием следует в одно и то же время. Суточная дозировка составляет 1 таблетку, которую необходимо запивать большим количеством воды.
Если женщина забыла принять таблетку, сделать это нужно как можно быстрее. Если же она вспомнила об этом уже на следующий день, не нужно употреблять сразу 2 таблетки. Дальнейшее употребление осуществляется по стандартной схеме.
Продолжительность терапевтического курса составляет 3-6 месяцев. После этого специалист осматривает пациентку. В некоторых случаях этого времени достаточно для нормализации гормонального фона, в других требуется более длительное применение.
При пропуске 3 и более таблеток существует риск развития вагинального кровотечения. В этом случае необходимо возобновить прием по стандартной схеме и обратиться к специалисту. Возможно, он назначит средства для остановки кровотечения. В каждом случае длительность применения может отличаться в зависимости от выраженности симптомов климакса.
Отзывы
Мнения специалистов и пациентов о данном препарате преимущественно положительные. По результатам статистики при соблюдении всех правил и дозировки приема появление нежелательных эффектов наблюдается крайне редко. Однако эндокринологи предупреждают, что самолечение медикаментом категорически запрещено. Использовать таблетки ЗГТ при менопаузе можно только после полного обследования организма и исключения всех возможных противопоказаний.
Что рассказывают о препарате Angeliq пациенты и врачи
Валерия Евгеньевна, 54 года
Принимаю эти таблетки уже 6 лет. Во время приема не беспокоят приливы и другие симптомы, но примерно год назад решила отказаться от терапии, практически сразу возобновились приливы. Гинеколог сказала нужно дальше пить, побочных эффектов не наблюдается. Сколько еще придется пить, даже не знаю, но опять бросать страшно.
Светлана, 48 лет
Добрый день всем! Angeliq стал для меня настоящим спасением. Первые симптомы менопаузы появились рано, только исполнилось 40 лет. Сначала пробовала гомеопатию, но эффекта практически не было. Доктор посоветовал эти таблетки, все наладилось и самое главное, чувствую себя полноценной женщиной, нет проблем в сексуальной жизни, чему муж мой несказанно рад! Всем советую, но конечно после консультации с доктором. Женщины, не отказывайтесь от радостей жизни, с этими таблетками жить проще.
Александра Сергеевна, гинеколог-эндокринолог
Как специалист знаю, насколько опасно не лечить климактерический синдром. Сама, вступив в эту непростую фазу, сразу начала прием гормонов. Чувствую себя отлично, могу полноценно работать и дарить женщинам здоровье. Пациенткам советую не затягивать с обращением к гинекологу и не заниматься самолечением. При корректной терапии опасности от ЗГТ нет.
Ольга, 49 лет
А мне мой доктор прописала Фемостон. Принимаю уже 4 года. В первые месяцы были побочки, приходилось корректировать дозу. Читаю отзывы женщин при климаксе и у меня вопрос к специалистам, а можно перейти после фемостона на анжелик? Или в этом нет смысла?
Александра Сергеевна, гинеколог-эндокринолог
Здравствуйте Ольга. Вопрос о смене препарата ЗГТ нужно решать со своим лечащим доктором. Если сейчас нет побочных эффектов, и организм хорошо переносит фемостон, то особого смысла в смене лекарственного средства нет. Если же присутствуют недомогания, есть смысл обратиться к специалисту и после обследования сменить медикамент.
Татьяна, 52 года
Не понимаю, зачем Фемостон на что-то менять. Для меня это единственное что действительно помогает. Перепробовала многие растительные и гормональные лекарства, но только фемостон оказался для меня эффективным. Хотя подруге он совсем не подошел, много побочек было и самочувствие только ухудшилось. Поэтому, если вам что-то подходит, не советую менять, вдруг хуже будет.
Регина, 45 лет
А мне гормоны не разрешили использовать. Много противопоказаний. Завидую тем, кому можно, ведь я уже 4 года просто мучаюсь. Никакие растительные добавки не снимают тяжелые приливы и остальные прелести менопаузы. Остается только ждать, когда это все кончится, моя жизнь похожа на ад, без сна, отдыха и личной жизни.
Оксана Валерьевна, 41 год
Вчера была в женской консультации. Без анализов и обследований назначили гормоны, корректное ли решение доктора о гормонозаместительной терапии? Операций не было, появились приливы и потоотделение. Подскажите, что делать.
Александра Сергеевна гинеколог-эндокринолог
Здравствуйте Оксана. Начинать гормонозаместительную терапию без полного обследования категорически нельзя. Я советую Вам обратиться в другое медицинское учреждение, где вам будет составлен корректный индивидуальный график лечения.
Анжелик — отзывы врачей
Сегодня в арсенале врачей имеется масса средств, которые способны облегчить климактерические симптомы у женщин. В их число входят как гормональные, так и не гормональные лекарственные средства, но Angeliq среди всех этих лекарств занимает особое место.
По мнению гинекологов это один из наиболее безопасных и эффективных препаратов ЗГТ, имеющийся сегодня на рынке. Действие активных компонентов прекрасно восполняет недостаток собственных гормонов при менопаузе, предупреждая при этом развитие многих возрастных заболеваний, в том числе онкологии матки и яичников.
По заявлению специалистов статистика неприятных побочных явлений при приеме Angeliq невелика. При соблюдении дозировки и графика приема осложнения появляются крайне редко. Однако гинекологи не советуют бросать терапию самостоятельно. Выход из ЗГТ должен быть плавным, путем снижения дозировки и только по разрешению лечащего врача. В общей массе Анжелик как лекарство при климаксе имеет положительные отзывы врачей и пациенток, но нужно понимать, что все сугубо индивидуально и выбор медикамента всегда остается за врачом.
Лекарственное взаимодействие
Анжелик таблетки от климакса не используется в сочетании с другими медикаментами на основе эстрадиола и дроспиренона. Препарат также не назначают одновременно со средствами, в составе которых имеется экстракт зверобоя продырявленного.
Существует несколько препаратов, которые ослабляют действие Анжелик:
- Карбамазепин.
- Рифампицин.
- Примидон.
- Фенитоин.
- Фелбамат.
Если пациента принимает гипотензивные и гипогликемические средства на постоянной основе, необходимо сообщить об этом лечащему врачу. Возможно, некоторые из средств несовместимы с гормональными медикаментами.
Концентрация активных компонентов в крови значительно повышается при приеме противогрибковых медикаментов и антибиотиков из группы макролидов. Помимо этого, алкогольные напитки усиливают действие эстрадиола и дроспиренона. Важно также знать, что препараты для снижения давления действуют более эффективно при одновременном приеме с Анжелик.
Отечественные и иностранные аналоги
При невозможности использовать оригинальное средство, врач назначает заменитель с похожим составом и терапевтическими свойствами.
Препараты могут быть отечественного или иностранного производства:
- Трисеквенс – препарат, который производится в Дании, содержит эстрадиол и норэтистерон. Назначается пациенткам при климаксе, когда симптомы его значительно ухудшают качество жизни. Принимают таблетки по 1 штуке в сутки в одно и то же время. Длительность курса составляет 3-6 месяцев.
- Дивина – германский препарат на основе эстрадиола, обладающий выраженным действием. Помогает облегчить симптомы климакса, нормализует гормональный фон и предотвращает различные осложнения со стороны сосудов, сердца и опорно-двигательного аппарата.
- Ци-клим – растительный аналог медикамента, выпускаемый российской компанией Эвалар. В составе содержит экстракт цимицифуги, который оказывает действие, подобное эстрогену. При этом симптоматика климакса ослабляется, а общее состояние пациентки улучшается.
Существует еще множество аналогов средства, но в каждом случае решение о назначении того или иного медикамента принимает врач. Настоятельно не рекомендуется самостоятельно подбирать заменитель.
Гормональный препарат Анжелик популярный и действенный. Таблетки используются не только от климакса, но и с целью профилактики заболеваний опорно-двигательного аппарата. При правильном применении медикамента вероятность побочных реакций снижается к минимуму.
Оформление статьи: Владимир Великий
Фемостон или Анжелик — что лучше?
Гормональный профиль женского организма на протяжении жизни проходит три стадии: созревание и подготовку к деторождению, детородный период и менопаузу. Их можно сравнить с весной, летом и осенью.
Для того чтобы максимально облегчить переход от репродуктивного «лета» к спокойной «осени», служат современные гормональные препараты.
Ниже рассказывается о двух из них и приводится их краткий сравнительный анализ.
Гормональные препараты применяются только по назначению врача
Это комбинированные лекарства для заместительной терапии женской репродуктивной системы при менопаузе. Если Анжелик и Фемостон сравнить по ключевым компонентам, то выяснится, что оба препарата содержат эстрадиол. Другой гормон в их составе отличается: в Анжелике присутствует дроспиренон, а в Фемостоне — дидрогестерон.
Анжелик выпускается фирмой Байер (Германия) в виде таблеток с двумя дозировками эстрадиола (по 1 и 0,5 мг) и дроспиренона (по 2 и 0,25 мг).